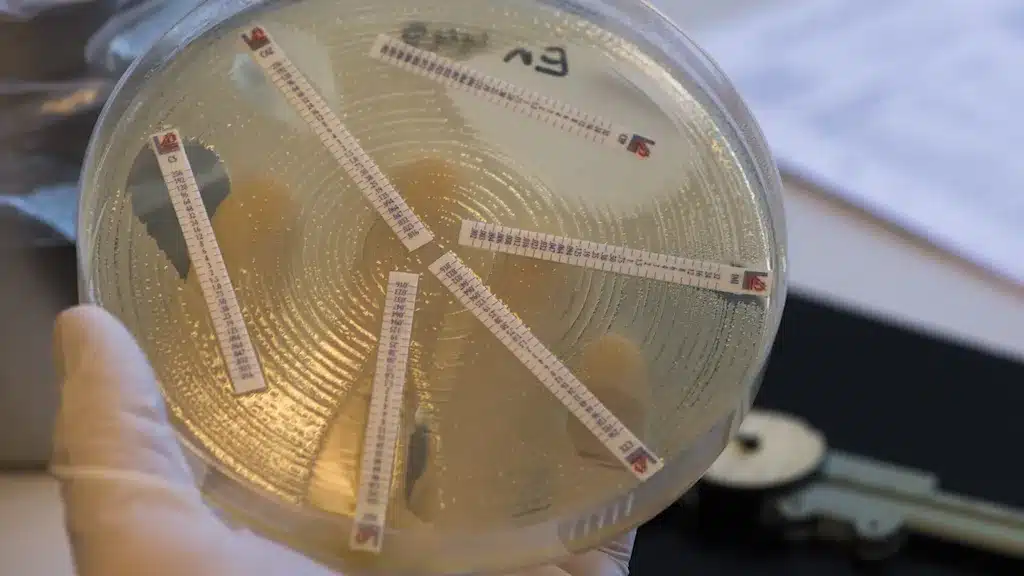

- В прошлом году устойчивость к антибиотикам в Швеции возросла, в то же время в стране было использовано больше антибиотиков.
- Об этом говорится в отчете Агентства общественного здравоохранения (Folkhälsomyndigheten) и шведского ветеринарно-медицинского института.
- Чем больше применяют антибиотики, тем больше возрастает устойчивость (резистентность) бактерий к лекарствам.